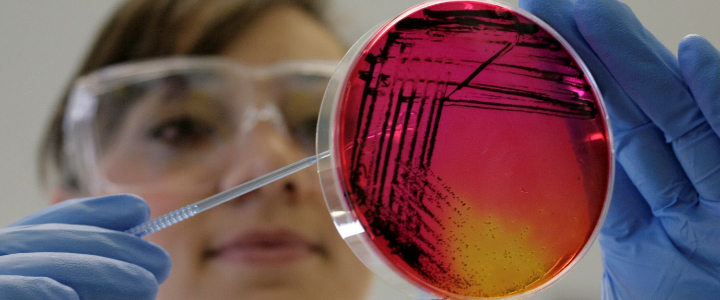
Microbiology

Microbiology, Brewing and Biotechnology
We conduct world-leading research across all aspects of microbiology and biotechnology.
Our research ranges from fundamental science, exploring both pathogenic and non-pathogenic bacteria, viruses and microbial eukaryotes, to applied microbiology in brewing and biotechnology. Our work is carried out in well-equipped laboratories, with full category level two biosafety facilities. We also host the National Centre for Macromolecular Hydrodynamics and have an on-site 1,000 L research brewery. Our research is broadly grouped under the themes shown below.

Our academics contribute to teaching a BSc (Hons) in Microbiology, BSc (Hons) and MSci in Biotechnology, as well as a range of Postgraduate Brewing qualifications and the National Brewing Apprenticeship training. We also run a highly successful, interdisciplinary MSc in Biotechnology, allowing students to study microbial, plant or animal biotechnology. In addition, we welcome applications for MRes and PhD degrees across all themes and are always happy to hear from those who would like to apply for postdoctoral fellowships.
Explore our research groups and centres
Applied Microbiology
The application of molecular biology to research on micro-organisms of importance to industry.
Applied Microbiology
Brewing Science
Our centre for brewing technologies is working with industry to resolve modern brewery challenges.
Brewing Science
One Health Microbiology
We recognise that human health is intimately linked with the health of the environment and of other animals.
One Health Microbiology
Structural Biology and Vaccines
Many researchers have an interest in structural biology and the development of vaccines for both human and animal disease.
Structural Biology and Vaccines